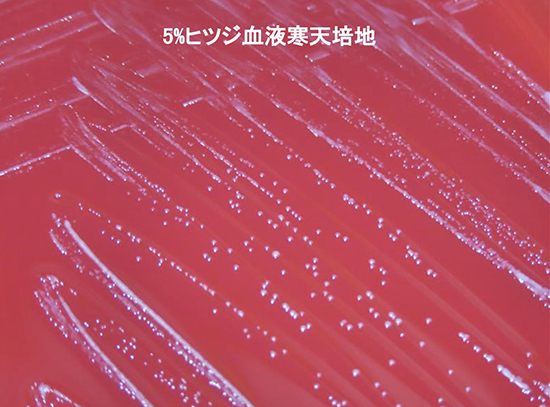

Cutibacterium acnes
「コンタミ」——血液培養でCutibacterium acnesが発育したとき、多くの臨床家が最初にそう判断します。しかしその判断が、人工関節に潜む感染症や感染性心内膜炎を見逃すことにつながるかもしれません。今回のMicrobiology roundでは、"ありふれた皮膚常在菌"という仮面をまとった病原体、Cutibacterium acnesを深掘りしました。
【語源】
Cutis: 皮膚、acnes: ニキビ
【歴史】
・1896 年に初めてacne bacillus として報告され、1900年にBacillus acne と命名された1)。
・Propionibacterium acnes を経て、2016年にCutibacterium acnes に変更された1)。
・遺伝的・形態的に異なる3亜種があり、C. acnes subsp. acnes(フィロタイプI)、C. acnes subsp. defendans(フィロタイプII)、C. acnes subsp. elongatum(フィロタイプIII)と命名されている。さらに6つの主要フィロタイプ(IA₁、IA₂、IB、IC、II、III)に区別されている2)。
【微生物学的特徴】
・好脂性グラム陽性菌2)。
・培養陽性までの平均は4.5日(範囲3~14日)3)
・カタラーゼなどの酵素を有するため酸素存在下でも生存可能な通性嫌気性菌である4)。
・血液寒天培地上では嫌気条件下で小型、半透明~灰白色のコロニーを形成する5)。
【臨床像】
・C. acnesは健康な成人の皮膚、特に顔面と上半身の皮脂腺に定着している。脂質を好むため皮脂の分泌量が多い顔や背中に多いといわれている。思春期に複数菌株(主にフィロタイプIA₁、IB、タイプII)による定着が増加する2)。
・尋常性ざ瘡患者と健常者の毛包内におけるC. acnesの量はほぼ同等(87〜89%)、または健常者でわずかに高い(94% vs. 89%)。量的な差ではなく、フィロタイプの差が尋常性ざ瘡に関連していると考えられる6)。
・IA1はニキビができやすい皮膚に多く見られ、IB、II、IIIは健康な皮膚に多く見られる1)。
・IB および II は整形外科感染症に関連している1)。
・バイオフィルムの形成は、C. acnesの病原性における重要な側面の一つ1)。
・インプラント留置のある骨や関節の感染症の起炎菌になる7)。
・肩には、周囲に皮脂腺が多く存在するため、他の部位よりもC. acnesによる関節炎を起こしやすい8)。
・C . acnes が関与する術後椎間板炎は、主に中年層に発症し、硬膜外膿瘍を合併することは稀で、先行する侵襲的手術から感染までは長い潜伏期間(平均約34ヶ月)がある9)。
・C. acnes単一菌による重度の頭蓋底骨髄炎の症例も報告されている10)。
・眼内レンズ、脳室腹腔内シャント、人工弁はC. acnesの感染リスクが高まる11)。
・SAPHO症候群(Synovitis[滑膜炎]、Acne[ざ瘡]、Pustulosis[膿疱症]、Hyperostosis[骨増殖症]、Osteitis[骨炎]の略)の骨関節病変から検出されることが多く、関連が報告されている12)。
【治療】
・肩の人工関節関節炎のreviewでは、検査した分離株はすべて、β-ラクタム (ペニシリン、ピペラシリン/タゾバクタム、エルタペネム)、バンコマイシン、モキシフロキサシン、およびリファンピシンに感性だった。嫌気性菌であるのにも関わらず、すべてがメトロニダゾールに耐性。クリンダマイシン耐性率は6% だった。ミノサイクリンのMIC範囲は0.03~0.25µg/mL(ミノサイクリンのCLSI、EUCASTのブレイクポイントはなし) 2)。
・C. acnesにおける抗菌薬耐性は1970年代に初めて報告され、1980年代には皮膚科領域における主要な問題として認識されるようになった。
・クリンダマイシン、エリスロマイシンへの耐性が認められており、ドキシサイクリン、ミノサイクリンへの耐性も増加傾向にある。1)
1) Karar W, Mohamed SA, Subramaniam G, Elamin Yousif ZY, Atron B, Dawoud ED, Khalingarajah H, Sivasamugham LA. Battling biofilms: evaluating selected agents against Cutibacterium acnes-a review. PeerJ. 2026 Jan 28;14:e20652.
2) Trends in Microbiology, April 01, 2023, Volume 31, Issue 4, Pages 419-420.
3) Piggott DA, Higgins YM, Melia MT, Ellis B, Carroll KC, McFarland EG, Auwaerter PG. Characteristics and Treatment Outcomes of Propionibacterium acnes Prosthetic Shoulder Infections in Adults. Open Forum Infect Dis. 2015 Dec 9;3(1):ofv191.
4) Mayslich C, Grange PA, Dupin N. Cutibacterium acnes as an Opportunistic Pathogen: An Update of Its Virulence-Associated Factors. Microorganisms. 2021 Feb 2;9(2):303.
5) Corvec S. Clinical and Biological Features of Cutibacterium (Formerly Propionibacterium) avidum, an Underrecognized Microorganism. Clin Microbiol Rev. 2018 May 30;31(3):e00064-17.
6) Dréno B, Pécastaings S, Corvec S, Veraldi S, Khammari A, Roques C. Cutibacterium acnes (Propionibacterium acnes) and acne vulgaris: a brief look at the latest updates. J Eur Acad Dermatol Venereol. 2018 Jun;32 Suppl 2:5-14.
7) Mandell, Douglas, and Bennett's Principles and Practice of Infectious Diseases. 10th
8)Levy PY, Fenollar F, Stein A, Borrione F, Cohen E, Lebail B, Raoult D. Propionibacterium acnes postoperative shoulder arthritis: an emerging clinical entity. Clin Infect Dis. 2008 Jun 15;46(12):1884-6.
9) Uçkay I, Dinh A, Vauthey L, Asseray N, Passuti N, Rottman M, Biziragusenyuka J, Riché A, Rohner P, Wendling D, Mammou S, Stern R, Hoffmeyer P, Bernard L. Spondylodiscitis due to Propionibacterium acnes: report of twenty-nine cases and a review of the literature. Clin Microbiol Infect. 2010 Apr;16(4):353-8.
10) Schopper HK, Hatch JL, Meyer TA. Propionibacterium acnes as an emerging pathogen in skull base osteomyelitis: A case series. Laryngoscope. 2018 Feb;128(2):332-335.
11) Achermann Y, Goldstein EJ, Coenye T, Shirtliff ME. Propionibacterium acnes: from commensal to opportunistic biofilm-associated implant pathogen. Clin Microbiol Rev. 2014 Jul;27(3):419-40.
12) Corbisiero MF, Batta N, Kyllo H, Smyth A, Allen L, Franco-Paredes C. Clinical spectrum of Cutibacterium acnes infections: The SAPHO syndrome. IDCases. 2023 May 4;32:e01784.

このサイトの監修者
亀田総合病院
臨床検査科部長、感染症内科部長、地域感染症疫学・予防センター長 細川 直登
【専門分野】
総合内科:内科全般、感染症全般、熱のでる病気、微生物が原因になっておこる病気
感染症内科:微生物が原因となっておこる病気 渡航医学
臨床検査科:臨床検査学、臨床検査室のマネジメント
研修医教育